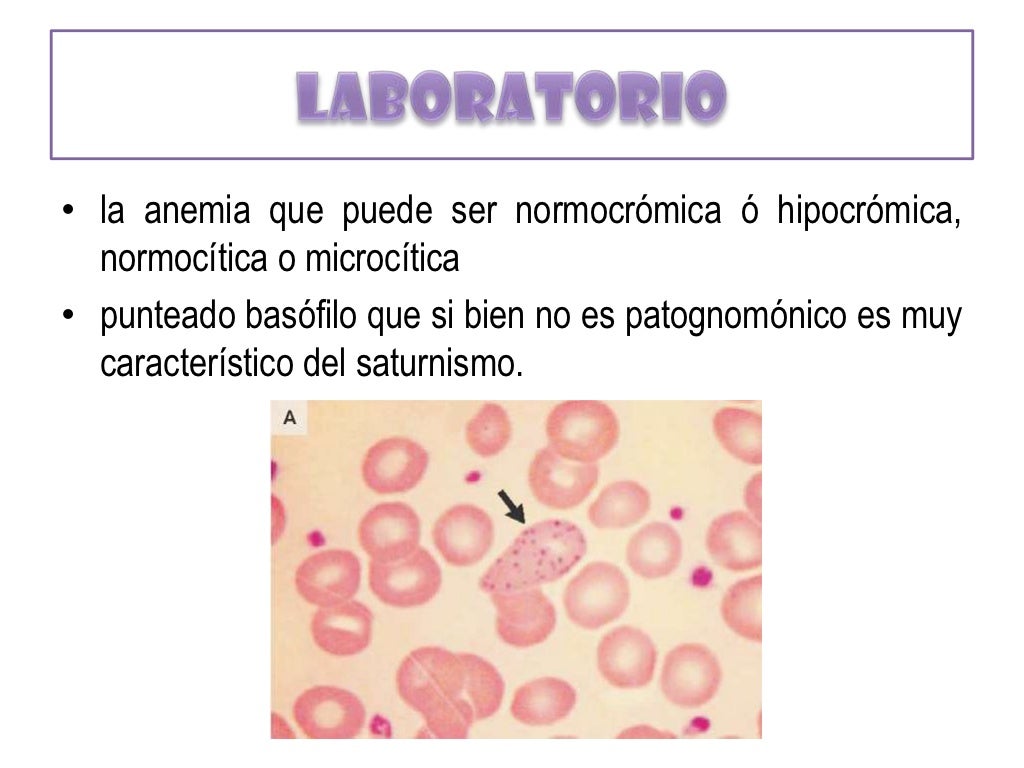
Saturnismo

Il saturnismo è una grave malattia cronica dovuta all'esposizione professionale o accidentale al piombo. Il nome deriva da Saturno, il dio romano associato dagli alchimisti a questo metallo. L'assimilazione di tale prodotto, soggetto a biomagnificazione, può avvenire per vie cutanee, mucose, inalazione o tramite l'apparato digerente (o picacismo).
Storia
Dioscoride Anazarbeo fu il primo ad ipotizzare la tossicità del piombo. Numerosi personaggi storici hanno probabilmente sofferto di saturnismo.
Il saturnismo era molto diffuso nell'Antica Roma, a causa dell'uso di pentoloni di piombo, tubature (ma solo quando erano appena posate) e principalmente per l'uso di vino tenuto in otri di piombo e addolcito con il diacetato di piombo; questo sale era il principale componente dello "zucchero di Saturno", un dolcificante molto usato all'epoca, prodotto facendo bollire e concentrare il mosto in pentoloni di piombo. Una contestata ipotesi vuole l'avvelenamento da piombo come concausa della sterilità diffusa e della decadenza dell'Impero Romano. Lo studioso Jerome Nriagu, nel volume Lead and Lead Poisoning in Antiquity (1983), e altri autori, hanno ipotizzato che alcuni imperatori romani particolarmente eccentrici o paranoici, sofferenti di non chiarite patologie o con apparenti problemi psichici, come Tiberio in età avanzata, Caligola, Claudio, Domiziano, Commodo e Nerone (tutti descritti come grandi bevitori di vino) erano forse affetti da saturnismo. Anche altri imperatori, in totale 19 sui 30 di quelli analizzati da Nriagu, potrebbero essersi intossicati col piombo a causa del grande consumo di vino addolcito nel mondo romano; tra essi anche tre dei cosiddetti "cinque buoni imperatori", cioè Nerva, Traiano e Adriano, i quali non ebbero figli e soffrirono di gotta e vari problemi di salute.
La morte di personaggi famosi come Beethoven e Goya (nonché la loro sordità e i disturbi psicofisici che li afflissero), o i disturbi mentali di Van Gogh, sono stati attribuiti a saturnismo. Per i pittori si presume che l'intossicazione cronica sia dovuta al loro contatto con i colori; ad esempio, Goya inumidiva i pennelli con la bocca. Beethoven invece aveva assorbito il piombo tramite il vino del Reno a causa dell'abitudine di bere da una coppa di cristallo di piombo, oltre ad aggiungere il diacetato di piombo per rendere il vino più dolce, e forse anche a causa di farmaci a base di piombo usati all'epoca. Anche la morte di Caravaggio e i suoi disturbi caratteriali sono stati attribuiti al saturnismo e all'avvelenamento da mercurio, elementi usati nei colori e di cui le sue presunte ossa erano ricoperte. Un pittore che invece morì sicuramente a causa dell'intossicazione da piombo fu Tranquillo Cremona. Altri personaggi storici per cui è stato ipotizzato che soffrissero di saturnismo, oltre a diversi pittori, furono lo scrittore e poeta Heinrich Heine e il compositore Georg Friedrich Händel.
Secondo altri studi è possibile che Giorgio III del Regno Unito, solitamente ritenuto affetto da porfiria acuta intermittente (malattia che presenta molti sintomi in comune col saturnismo) che gli causò infermità mentale prolungata e altri disturbi, fosse in realtà intossicato da piombo e arsenico a causa delle pentole che utilizzava. Anche i linotipisti (addetti alla linotype) venivano spesso a contatto con il piombo rimasto nella camera di fusione nella macchina e potevano riportare i sintomi dell'avvelenamento da piombo, così come chi lavorava a contatto con la vecchia benzina o con vernici a piombo; altre figure professionali spesso vittime di saturnismo erano i cappellai, che usavano misture di piombo, mercurio e arsenico per la colorazione dei tessuti. Questo ultimo caso ispirò a Lewis Carroll la figura del Cappellaio Matto.
Un'ipotesi alternativa vuole che il saturnismo abbia causato anche la morte precoce del leader bolscevico russo Lenin (ufficialmente deceduto per aterosclerosi dopo un anno di malattia nel 1924), ferito da alcuni proiettili nel 1918, che furono rimossi solo nel 1922.
In tempi più recenti, il ciclista statunitense Greg LeMond fu vittima nel 1987 di un incidente di caccia nel quale fu colpito da numerosi pallini, molti dei quali rimasero all'interno del suo corpo. Si riprese brillantemente, riuscendo a vincere nel 1989 e 1990 il suo secondo e terzo Tour de France, ma la sua carriera finì molto presto, proprio per il lento avvelenamento da piombo.
Con l'eliminazione del piombo dai carburanti statunitensi, il livello del piombo nel sangue dei bambini fino a 5 anni si è ridotto dell'80% e nei test di intelligenza effettuati su bambini in età prescolare si sono riscontrati medie tra 2,2 e 4,7 punti, superiori al decennio precedente.
Eziologia
Il piombo puro è un metallo malleabile e pesante di colore grigio scuro per la presenza di ossidazione superficiale; fonde a 327,46 °C, con emissione di vapori a circa 450 °C. L'ebollizione avviene invece a circa 1740 °C. In natura si ritrova nella galena (solfuro di piombo), cerussite (carbonato di piombo), anglesite (solfato di piombo) o associato a zinco, argento e rame. Può essere utilizzato allo stato puro, in lega con altri metalli o per la produzione di composti inorganici o come piombo tetraetile, antidetonante per i vecchi combustibili.
Il piombo è un metallo velenoso, che può danneggiare il sistema nervoso, specialmente quello nei bambini, e causare malattie del cervello e del sangue. L'esposizione al piombo o ai suoi sali, soprattutto a quelli solubili, o all'ossido PbO2 può causare nefropatie, caratterizzate dalla sclerotizzazione dei tessuti renali, e dolori addominali colici. Nefropatie croniche ed encefalopatie sono state rilevate sia in forti bevitori di whisky di contrabbando, in quanto la saldatura delle serpentine di distillazione è costituita da piombo, sia in utilizzatori di stoviglie smaltate a piombo. Inoltre altre categorie a rischio di intossicazione sono i lavoratori dell'industria e dell'artigianato.
Fonti di rischio
L'intossicazione da piombo può avvenire sia nell'ambiente lavorativo sia occasionalmente, gli esposti al rischio professionale sono:
- Addetti alla estrazione o alla fusione del piombo;
- Addetti alla saldatura;
- Addetti alla produzione o smaltimento di batterie ricaricabili;
- Addetti alla produzione o all'uso di vernici contenenti piombo;
- Addetti alla produzione di oggetti di cristallo;
- Addetti alla produzione di pallini da caccia o da pesca;
- Addetti alla produzione di leghe o oggetti contenenti piombo;
- Tiratori con armi da sparo utilizzanti proiettili in piombo e/o leghe di piombo, inneschi (primers) contenenti piombo;
- Direttori, commissari e istruttori di tiro utilizzanti armi da sparo utilizzanti proiettili in piombo e/o leghe di piombo, inneschi (primers) contenenti piombo. Soggetti a rischio anche se minore gli addetti alla pulizia e manutenzione di armi e poligoni di tiro;
- Restauratori;
- In passato i cappellai e benzinai erano particolarmente esposti, fino a quando non è entrato in vigore l’obbligo di legge che proibì l’uso di additivi piombici nei carburanti;
- Ricercatori che hanno a che fare con la perovskite.
Accidentalmente, l'esposizione cronica da piombo può avvenire con il consumo di alimenti e bevande (talora anche aceto) stoccati in vecchi contenitori di ceramica o contenenti piombo. Altre volte il piombo si trova diffuso dall'uomo nell'ambiente in:
- Aria: uso di pesticidi contenenti piombo; in passato anche nello smog prodotto da automobili alimentate a benzina con piombo, usata fino al 2002 (possibili danni in persone che hanno respirato a lungo tali fumi).
- Suolo e acqua: processi industriali, pallini da caccia e da pesca, inquinamento falde acquifere, vecchie tubature in piombo.
Particolare attenzione deve essere rivolta ai bambini per la possibile ingestione di oggetti contenenti piombo (picacismo) e soprattutto per la maggiore sensibilità all'effetto tossico del metallo. Ulteriore attenzione deve essere posta quando i bambini sono nel periodo nel quale spuntano i primi denti: per alleviare il prurito, in alcuni casi potrebbero mordere delle ringhiere e, tramite azione corrosiva della saliva, il diretto contatto con la gengiva può farne assorbire gli elementi di piombo oltre il rivestimento esterno della ringhiera. Nei lattanti, il piombo può essere assunto tramite depositi di sali sul capezzolo materno. In passato, l'uso di copricapezzoli di piombo per la cura delle ragadi della areola mammaria ha determinato frequenti intossicazioni saturniche; il divieto dell'utilizzo di tali sistemi ha drasticamente ridotto l'incidenza di questa intossicazione in età pediatrica. Più importante è inoltre la frazione assorbita dalle cellule intestinali del bambino.
Il consumo di selvaggina con tracce di piombo da munizioni può essere pericoloso.
Tossicocinetica
Il piombo può essere assunto per via respiratoria o per ingestione. La prima via è importante nei soggetti esposti ai fumi o vapori della lavorazione del piombo o delle sue leghe. Questa via è molto importante in quanto le piccole particelle che raggiungono i polmoni sono assorbite in una quota di poco inferiore al 50%. Particelle di diametro maggiore, polveri ingerite per contaminazione di cibo, liquidi o tessuti, raggiungono invece il tratto gastrointestinale dove circa il 10% negli adulti e il 40% nei bambini sono assorbite. Una volta assorbito, il piombo si distribuisce in larga parte negli eritrociti e, in una piccola frazione (circa il 10%), nel plasma. Di qui è libero di distribuirsi in diversi compartimenti corporei. Tra questi:
- Tessuti molli, con cinetica di ridistribuzione rapida. Questa frazione è responsabile dell'effetto tossico.
- Osso spongioso, muscoli e apparato tegumentario, con cinetica di ridistribuzione intermedia.
- Capelli, denti e osso compatto. In quest'ultimo può rimanere anche per venti anni. Benché sia tendenzialmente inattivo dal punto di vista tossicologico, il piombo immagazzinato rappresenta una quota prontamente disponibile in caso di fratture e alterazioni del tessuto osseo.
L'eliminazione del piombo ingerito è prevalentemente fecale, con quota escreta pari al 60% nel bambino e al 90% nell'adulto. La via urinaria rappresenta invece un affidabile indicatore di dose assorbita; analogamente il piombo assorbito può passare nel latte materno o attraverso la placenta (a partire dalla tredicesima settimana).
Patogenesi
L'azione tipica del piombo si esplica sull'emopoiesi, bloccando la funzione di diversi enzimi preposti alla sintesi dell'eme. Questo effetto, unitamente all'effetto citotossico eritrocitario con iperemolisi, è responsabile della anemia ipocromica e della escrezione urinaria dei composti a monte della via dell'eme. Infatti l'effetto inibitorio sull'enzima ALA deidratasi porta all'accumulo di acido delta aminolevulinico mentre l'effetto su coproporfirinogeno III ossidasi e su eme ossidasi è responsabile dell'accumulo di coproporfirinogeno III e protoporfirina IX rispettivamente. Il piombo può inibire alcuni enzimi agendo sui gruppi sulfidrilici liberi impedendo che possano essere utilizzati da enzimi a cui sono indispensabili.
Il piombo ostacola la sintesi dell'eme che nel sangue conduce ad una diminuzione dei globuli rossi e dell'emoglobina racchiusa in ogni globulo. Un malato intossicato da piombo produce globuli rossi alterati, definiti "punteggiati", e questo fatto può condurre all'anemia. A livello dell'apparato gastroenterico il piombo è invece responsabile della colica saturnina, dolore addominale di tipo spastico dovuto alla diretta azione del piombo sulla muscolatura liscia intestinale parzialmente risolvibile con spasmolitici.
A questa si associa stipsi e meteorismo, manifestazioni tipicamente preceduti da dolenzia addominale diffusa e sapore metallico in bocca. La deposizione del metallo in sede gengivale è responsabile del colorito bluastro visibile a livello del colletto degli incisivi esterni e dei canini. Il piombo (grave esposizione acuta o subacuta) esplica inoltre effetti tossici diretti a livello del sistema nervoso centrale per spasmo delle arteriole e conseguente edema cerebrale diffuso. Il sistema nervoso periferico è invece interessato nelle forme croniche, con polineuropatia e paralisi periferica (tipica paralisi del nervo radiale).
I reni possono essere l'obiettivo della tossicità da piombo sia acutamente che cronicamente; infatti l'effetto tossico diretto sull'epitelio tubulare e lo spasmo delle arteriole renali può essere responsabile di un'insufficienza renale acuta di tipo renale con proteinuria e cilindruria grave. L'esposizione cronica provoca invece il cosiddetto rene grinzo saturnino, condizione di insufficienza renale cronica dovuta all'ischemia cronica per spasmo arteriolare. La conseguente ipertensione arteriosa è responsabile dell'aumentato rischio cardiovascolare nei soggetti esposti a piombo. La gotta saturnina è invece dovuta alla diminuita escrezione di acido urico.
Le preoccupazioni per il ruolo del piombo nel ritardo mentale nei bambini ha portato ad una generale riduzione del suo uso. L'esposizione prolungata a bassi livelli di piombo è stata collegata anche alla schizofrenia o al tremore essenziale, nonché all'aumento dell'aggressività e dei reati violenti, del cancro e alle malattie neurodegenerative.
Clinica
Intossicazione acuta
I sintomi della rara intossicazione acuta sono:
- Nausea, vomito, diarrea, intensi dolori addominali
- Anemia emolitica
- Ittero per epatopatia (anche lieve)
- Insufficienza renale acuta
In caso di intossicazione massiva può eccezionalmente insorgere la gravissima encefalopatia saturnina:
- Convulsioni
- Ipertensione cerebrale
- Edema cerebrale
quindi sopraggiunge la morte.
Richiede con urgenza una terapia chelante: edetato sodico calcico (CaNa-EDTA) con supplementazione di zinco.
Intossicazione cronica
L'intossicazione cronica può essere di tipo occupazionale (esposizione lavorativa) o incidentale. Il Centro per il Controllo e la Prevenzione delle Malattie (CDC) degli Stati Uniti ha stabilito un limite superiore per la piombemia (livello di piombo nel sangue) a 10 µg/dL per gli adulti e 3,5 µg/dL per i bambini. Tuttavia, l'Organizzazione Mondiale della Sanità afferma che non esiste un livello sicuro di esposizione al piombo e raccomanda di identificare e affrontare rapidamente la fonte di esposizione per gli individui con livelli di piombemia superiori a 5 µg/dL.
È stato dimostrato che la piombemia è correlata alla durata dell'esposizione e alla gravità dell'intossicazione, con sintomi più probabili e gravi negli adulti con livelli di piombemia superiori a 80 µg/dL. Il riconoscimento precoce dei sintomi, come mal di testa, disorientamento, debolezza, scarsa appetito, vomito, stitichezza, dolore addominale e alle articolazioni, e anemia, può contribuire a gestire rapidamente e limitare la gravità e le conseguenze neurologiche dell'avvelenamento da piombo.
Nello specifico, in caso di intossicazione cronica si può avere:
- anemia (con alterazioni eritrocitarie: aumento delle protoporfirine, per il blocco della via metabolica che porta alla sintesi di eme), alterazioni mitocondriali, eritrociti immaturi in circolo)
- disturbi trofici gengivali (orletto di Burton) che si origina per reazione del piombo presente nei capillari con l'idrogeno solforato dei residui alimentari
- nefrosclerosi con: ematuria, proteinuria, cilindruria, oliguria; col tempo insufficienza renale cronica
- colica saturnina: dolore addominale a cintura (tipo pancreatite) provocato dalla contrazione della muscolatura liscia della parete intestinale (attenuabile tramite gluconato di calcio), nausea vomito, stipsi, occlusione intestinale
- elevata incidenza di mortalità neonatale, documentata infertilità nella donna; nell'uomo si evidenziano anomalie spermatiche ed oligospermia, sterilità
- ipertensione
- paresi del radiale; la velocità di conduzione motoria risulta alterata per la demielinizzazione (neuropatia periferica da intossicazione);
- encefalopatia da piombo (molto frequente nei bambini, più rara nell'adulto), cefalea, amnesia
- tremore e vari sintomi extrapiramidali (parkinsonismo), astenia, parestesia, disturbi visivi (annebbiamento della vista) e uditivi (ipoacusia, sordità), paralisi
- disturbi neuropsichiatrici: alterazioni cognitive, irritabilità, nervosismo, disturbi psichici veri e propri (cambio della personalità, labilità emotiva, allucinazioni, paranoia, delirio), demenza
- sintomi sistemici, gastrointestinali e metabolici vari: anoressia, calo ponderale, dolori addominali, astenia degli estensori, colorito cinereo del volto, alterazione del metabolismo purinico, gotta acuta, nefropatia gottosa, artrite, oliguria, proteinuria, diarrea, vomito, nausea, sapore metallico, intensa sete
Diagnosi
Oltre a contesto anamnestico ed esame obiettivo, esistono indicatori di dose (esami che indicano la dose alla quali si è stati esposti) e indicatori di effetto (indicatori dell'effetto sull'organismo dell'esposizione al piombo).
Indicatori di dose
- Piombemia, corretta per la conta dei globuli rossi (talora gli stati anemici conseguenti all'esposizione al piombo possono dare falsi negativi), indicatore di esposizione. Non è un indicatore adatto per stimare le riserve tissutali.
- Piomburia, sempre corretta per la conta dei globuli rossi. Si eleva dopo due settimane; come per la piombemia, non è un indicatore adatto per stimare le riserve tissutali.
- Piombemia dopo somministrazione di 1 g di CaNaEDTA, agente chelante del piombo. Se elevata, indica la presenza di riserve tissutali.
Indicatori di effetto
- Acido delta aminolevulinico deidratasi eritrocitaria: la sua inibizione è l'indice più affidabile e più precoce di esposizione al piombo. Deve però essere ricordato che esposizioni croniche o recenti all'alcool possono inibire l'enzima.
- Protoporfirina IX eritrocitaria: la valutazione della concentrazione di questa molecola correla direttamente con l'azione biologica del piombo. Rimane elevata per alcuni mesi, rendendola efficace per valutare i depositi di piombo tissutale.
- Acido delta aminolevulinico urinario: aumenta in corso di intossicazioni da piombo e di porfiria acuta intermittente (con problemi di diagnosi differenziale).
- Coproporfirine urinarie: diminuiscono rapidamente dopo esposizione e rappresentano un buon indice di esposizione acuta.
Terapia
La terapia si basa sull'allontanamento dalla fonte e sulla somministrazione di un chelante del piombo, ossia il sale CaNa2EDTA endovena 1-2 g/die per cicli di 4-5 giorni, con sospensione di 2-3 settimane e poi ripresa. La terapia si deve continuare fino alla normalizzazione della piombemia, parametro che indica una diminuzione sostanziale delle riserve tissutali. Le coliche possono essere controllate con spasmolitici; si deve inoltre attuare una terapia atta a correggere l'eventuale disionia ed ipertensione.
Alcuni studi evidenziano che l'alga spirulina è un chelante del piombo in basse concentrazioni di 50 mg/litro (75% di assorbimento nei primi 12 minuti), che si ipotizza di utilizzare nella depurazione delle acque di scarico, in tutti gli organi dei ratti come inibitore della perossidazione lipidica indotta dal piombo. Se i chelanti vengono coltivati in acque contaminate, inevitabilmente divengono una fonte di intossicazione da metalli pesanti, perdendo ogni beneficio.
Prognosi
Gravi reliquati dell'intossicazione cronica non trattata comprendono:
- Nefropatia cronica (rene grinzo saturnino) con ipertensione arteriosa e insufficienza renale cronica
- Neuropatia periferica, encefalopatia su base tossica ed ipertensiva, danni permanenti al sistema nervoso centrale
- Gastrite cronica e duodenite, coliche persistenti
- Vasculopatia e cardiopatia ipertensiva
Saturnismo sulla fauna selvatica
Note
Bibliografia
- Bonsignore Alfredo, Ottenga Franco, Medicina del lavoro, ECIG, 2002, ISBN 978-88-7545-929-1.
- Harrison, Principi di Medicina Interna (il manuale - 16ª edizione), New York - Milano, McGraw-Hill, 2006, ISBN 88-386-2459-3.
Voci correlate
- Piombo
- Piombo tetraetile
- Emopoiesi
- Pallini da caccia
- Biomagnificazione
Altri progetti
- Wikizionario contiene il lemma di dizionario «saturnismo»
- Wikimedia Commons contiene immagini o altri file su saturnismo
Collegamenti esterni
- Piombo che uccide Archiviato il 13 febbraio 2014 in Internet Archive. del Corpo forestale dello Stato
- Il piombo nelle munizioni da caccia: problematiche e possibili soluzioni dell'Istituto Superiore per la Protezione e la Ricerca Ambientale